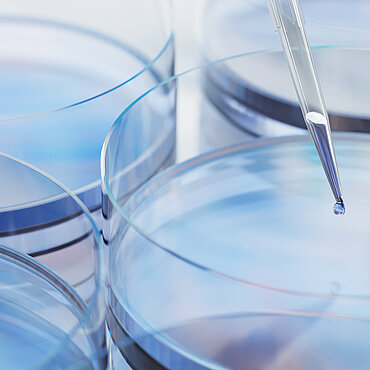

GvW Graf von Westphalen is a general partnership of attorneys at law and tax advisors with 250 legal professionals. With our offices in Berlin, Düsseldorf, Frankfurt am Main, Hamburg, Munich and Stuttgart, we are one of Germany’s largest independent law firms. We also provide advice to clients around the world – from our offices in Shanghai, Ho Chi Minh City, Istanbul and Brussels and through our membership in several highly respected global networks.
Our Focus Areas
GvW Graf von Westphalen has been providing comprehensive and successful advice in the automotive and mobility sectors for many years. The firm's lawyers support companies from Germany and abroad at all levels of the supply chain. The expertise of the competence team in the focus area includes, in particular, advising on questions of contract drafting, product safety/product liability and warranty law, as well as representation in judicial and extrajudicial proceedings. Another area of expertise is ESG & Sustainability. Our lawyers in the Automotive & Mobility focus area are also happy to provide support on labour, corporate and antitrust law issues or on the topics of digitalisation and data protection. By combining our various areas of expertise, we work with you to shape the mobility of the future – strategically, economically and from a single source.
GvW Graf von Westphalen has provided comprehensive advice in the aviation sector for many years. Here we advise in particular companies from the aerospace industry as well as numerous national and international commercial airports. In addition, we assist the airlines with all legal matters. In our Aviation Focus Area we have brought together specialists from various legal fields with expertise in the aviation industry. This allows us to work efficiently as a team and offer a one-stop shop for legal advice to our clients.
The continuing transformation in the banking and financial services sector happening in various legal fields is not least the result of the globalisation of markets, the financial crisis and frequent changes in rules in regulations. We have pooled our expertise in the finance area into a focus group in order to advise our clients successfully and effectively during such times. This allows us to draw on specialists across locations and legal fields to form a team with specific experience in advising banks and financial services institutions of any size.
As the march of digital transformation continues, its effects continue to be felt by people, society and the economy. Ongoing advances in data-based technologies are opening up opportunities for new business models in all industrial sectors. Mobility and digital networking are increasingly having an impact on day-to-day business and working life. Understanding, applying and shaping the legal environment in this process is the focus of our advice in this area, which we offer with many years of cross-sector experience and seasoned expertise in all major legal fields. In this way we make an effective contribution to preserving the interests of our clients and achieving their goals.
Scarcely any other industry has been witnessing a more rapid pace of development than the energy sector. Particularly with the German energy revolution, companies and the state find themselves confronted with new challenges as the focus pivots towards renewable energies and improving energy efficiency in addition to faster expansion of the grid. At the same time, shifting societal interests and political priorities are being accompanied by sweeping changes in the legislative environment. At GvW Graf von Westphalen we have many years of experience in the different areas of the energy industry. Thanks to our pooled expertise we can provide you with comprehensive assistance in your projects – whether national or international, onshore or offshore.
Strong environmental, social and governance practices are playing an increasing role in companies’ competitiveness. This is not only because of the greater attention these matters receive from the public but also to a number of legislative initiatives requiring companies to deliver greater transparency and to takeing specific action.
In the highly dynamic food industry, companies have to be ready for new developments all the time. Regularly changing consumer trends and consumer protection regulations as well as low margins call for a high degree of flexibility in this fiercely competitive market.
When it comes to providing legal advice to the sector, having expertise in numerous legal fields is indispensable. With our long-standing and specialist knowledge of the food industry, we can advise food companies on all manner of legal issues. We assist in all areas of the food industry, from small family businesses to large multinational groups.
The highly regulated healthcare & life sciences sector is driven by a constant change due to various factors, such as demographic change, reforms and digitalisation. That said, the healthcare & life sciences sector is facing complex legal and structural challenges. As experienced lawyers dedicated to the industry, we can comprehensively advise our clients on all relevant legal matters arising in the industry. Our work particularly focuses on the dynamic innovation and digital transformation process that many companies are currently undergoing. We offer tailored legal solutions for our clients.
The complex and distinctive legal structures found in the hotel industry call for combined efforts to leverage the multifaceted expertise in numerous specialty legal fields. Companies from the hospitality sector have long benefited from GvW’s hands-on working group in this focus area. The team has gained valuable expertise from numerous transactions and projects in this industry. We also act for investors, hotels, credit institutions and project managers alike, in both national and international projects.
GvW has a long history of providing legal advice to the state. For many decades we have advised federal and federal state ministries, towns and cities, municipalities, associations and public corporations, and have provided ongoing advice to private individuals in all manner of permit procedures.
The federal government, the states, districts and municipalities have to make challenging decisions. We know these situations and challenges faced by administrative practice. We are qualified to resolve and clarify complex issues and come up with appropriate and hands-on solutions as we work together with our clients.
The insurance industry plays one of the most important roles in the German economy. For years, one of GvW's key areas of activity has been advising all players with regard to their entire business operations and claims handling. Here, our clients from the insurance sector benefit from our specialisation and industry expertise as well as our thoroughgoing knowledge of their needs and expectations. As a full-service law firm and with the close cooperation of our team of specialists from different practice groups, we cover not just issues specific to insurance and supervisory law but all aspects of the business as well. We advise reputable domestic and non-domestic insurance undertakings, managing general agents (MGAs), insurance brokers, broker pools and insuretechs.
The quickening pace of digitalisation and globalisation is leading to a steadily changing legal environment in the maritime industry. With the help of our interdisciplinary team, you can navigate your way through the (often international) rules and regulations. In this way your contracts, transactions and projects are firmly anchored in a robust framework. We offer a one-stop shop for advice to companies from the logistics, port and shipping sector in all legal, industry-related matters. At the same time, we represent you in your dealings with national authorities and the European Commission as well as fiscal, civil, criminal and administrative courts including the Court of Justice of the European Union.
The real estate industry has been a focus area of GvW Graf von Westphalen ever since the law firm was established. With a view to ensuring comprehensive advice to our clients from the real estate industry, we have pooled our expertise from various legal areas in our Real Estate Focus Group. With industry knowledge and many years of experience in advising on issues specific to real estate, our 50 experts can provide advice as a one-stop shop. We have specialists qualified to advise on any specific issue – which is why we can answer questions especially quickly and efficiently. Our clients include real estate companies and real estate funds, but we also advise banks, insurance undertakings and the state on relevant real estate subjects.
The hopes of the German economy are increasingly being borne by young and highly innovative companies. With their ideas, thousands of startups in Germany alone are currently giving a big boost to the country’s future viability. Berlin, Frankfurt, Hamburg, Munich, Stuttgart and other metropolitan regions are proving attractive for launching international companies. In the past, we successfully advised young companies in incorporating and then expanding their businesses. With our interdisciplinary team, we can offer startups comprehensive assistance with all manner of legal matters such as questions of tax, employment, trade and tenancy law. For more information on our offering, visit www.startupberater.com.
GvW Graf von Westphalen has been providing comprehensive and successful advice in the automotive and mobility sectors for many years. The firm's lawyers support companies from Germany and abroad at all levels of the supply chain. The expertise of the competence team in the focus area includes, in particular, advising on questions of contract drafting, product safety/product liability and warranty law, as well as representation in judicial and extrajudicial proceedings. Another area of expertise is ESG & Sustainability. Our lawyers in the Automotive & Mobility focus area are also happy to provide support on labour, corporate and antitrust law issues or on the topics of digitalisation and data protection. By combining our various areas of expertise, we work with you to shape the mobility of the future – strategically, economically and from a single source.
GvW Graf von Westphalen has provided comprehensive advice in the aviation sector for many years. Here we advise in particular companies from the aerospace industry as well as numerous national and international commercial airports. In addition, we assist the airlines with all legal matters. In our Aviation Focus Area we have brought together specialists from various legal fields with expertise in the aviation industry. This allows us to work efficiently as a team and offer a one-stop shop for legal advice to our clients.
The continuing transformation in the banking and financial services sector happening in various legal fields is not least the result of the globalisation of markets, the financial crisis and frequent changes in rules in regulations. We have pooled our expertise in the finance area into a focus group in order to advise our clients successfully and effectively during such times. This allows us to draw on specialists across locations and legal fields to form a team with specific experience in advising banks and financial services institutions of any size.
As the march of digital transformation continues, its effects continue to be felt by people, society and the economy. Ongoing advances in data-based technologies are opening up opportunities for new business models in all industrial sectors. Mobility and digital networking are increasingly having an impact on day-to-day business and working life. Understanding, applying and shaping the legal environment in this process is the focus of our advice in this area, which we offer with many years of cross-sector experience and seasoned expertise in all major legal fields. In this way we make an effective contribution to preserving the interests of our clients and achieving their goals.
Scarcely any other industry has been witnessing a more rapid pace of development than the energy sector. Particularly with the German energy revolution, companies and the state find themselves confronted with new challenges as the focus pivots towards renewable energies and improving energy efficiency in addition to faster expansion of the grid. At the same time, shifting societal interests and political priorities are being accompanied by sweeping changes in the legislative environment. At GvW Graf von Westphalen we have many years of experience in the different areas of the energy industry. Thanks to our pooled expertise we can provide you with comprehensive assistance in your projects – whether national or international, onshore or offshore.
Strong environmental, social and governance practices are playing an increasing role in companies’ competitiveness. This is not only because of the greater attention these matters receive from the public but also to a number of legislative initiatives requiring companies to deliver greater transparency and to takeing specific action.
In the highly dynamic food industry, companies have to be ready for new developments all the time. Regularly changing consumer trends and consumer protection regulations as well as low margins call for a high degree of flexibility in this fiercely competitive market.
When it comes to providing legal advice to the sector, having expertise in numerous legal fields is indispensable. With our long-standing and specialist knowledge of the food industry, we can advise food companies on all manner of legal issues. We assist in all areas of the food industry, from small family businesses to large multinational groups.
The highly regulated healthcare & life sciences sector is driven by a constant change due to various factors, such as demographic change, reforms and digitalisation. That said, the healthcare & life sciences sector is facing complex legal and structural challenges. As experienced lawyers dedicated to the industry, we can comprehensively advise our clients on all relevant legal matters arising in the industry. Our work particularly focuses on the dynamic innovation and digital transformation process that many companies are currently undergoing. We offer tailored legal solutions for our clients.
The complex and distinctive legal structures found in the hotel industry call for combined efforts to leverage the multifaceted expertise in numerous specialty legal fields. Companies from the hospitality sector have long benefited from GvW’s hands-on working group in this focus area. The team has gained valuable expertise from numerous transactions and projects in this industry. We also act for investors, hotels, credit institutions and project managers alike, in both national and international projects.
GvW has a long history of providing legal advice to the state. For many decades we have advised federal and federal state ministries, towns and cities, municipalities, associations and public corporations, and have provided ongoing advice to private individuals in all manner of permit procedures.
The federal government, the states, districts and municipalities have to make challenging decisions. We know these situations and challenges faced by administrative practice. We are qualified to resolve and clarify complex issues and come up with appropriate and hands-on solutions as we work together with our clients.
The insurance industry plays one of the most important roles in the German economy. For years, one of GvW's key areas of activity has been advising all players with regard to their entire business operations and claims handling. Here, our clients from the insurance sector benefit from our specialisation and industry expertise as well as our thoroughgoing knowledge of their needs and expectations. As a full-service law firm and with the close cooperation of our team of specialists from different practice groups, we cover not just issues specific to insurance and supervisory law but all aspects of the business as well. We advise reputable domestic and non-domestic insurance undertakings, managing general agents (MGAs), insurance brokers, broker pools and insuretechs.
The quickening pace of digitalisation and globalisation is leading to a steadily changing legal environment in the maritime industry. With the help of our interdisciplinary team, you can navigate your way through the (often international) rules and regulations. In this way your contracts, transactions and projects are firmly anchored in a robust framework. We offer a one-stop shop for advice to companies from the logistics, port and shipping sector in all legal, industry-related matters. At the same time, we represent you in your dealings with national authorities and the European Commission as well as fiscal, civil, criminal and administrative courts including the Court of Justice of the European Union.
The real estate industry has been a focus area of GvW Graf von Westphalen ever since the law firm was established. With a view to ensuring comprehensive advice to our clients from the real estate industry, we have pooled our expertise from various legal areas in our Real Estate Focus Group. With industry knowledge and many years of experience in advising on issues specific to real estate, our 50 experts can provide advice as a one-stop shop. We have specialists qualified to advise on any specific issue – which is why we can answer questions especially quickly and efficiently. Our clients include real estate companies and real estate funds, but we also advise banks, insurance undertakings and the state on relevant real estate subjects.
The hopes of the German economy are increasingly being borne by young and highly innovative companies. With their ideas, thousands of startups in Germany alone are currently giving a big boost to the country’s future viability. Berlin, Frankfurt, Hamburg, Munich, Stuttgart and other metropolitan regions are proving attractive for launching international companies. In the past, we successfully advised young companies in incorporating and then expanding their businesses. With our interdisciplinary team, we can offer startups comprehensive assistance with all manner of legal matters such as questions of tax, employment, trade and tenancy law. For more information on our offering, visit www.startupberater.com.